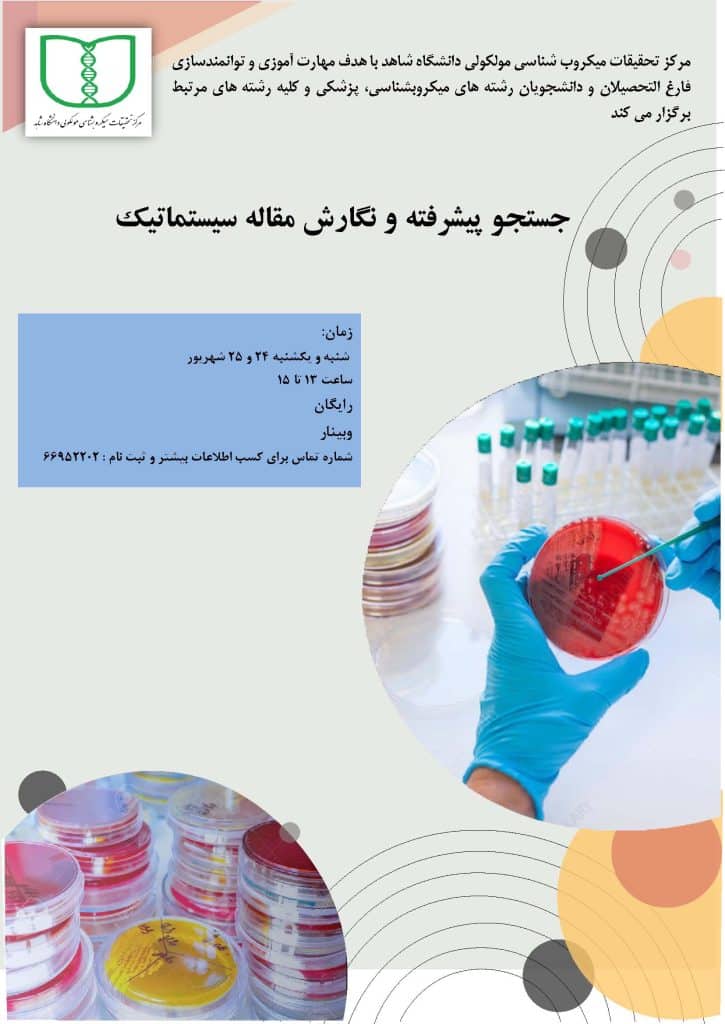

staphylococcus_aureus_bacteria_escape

Untitled(3)

Molecular-Microbiology-615x340

صفحه اول سایت

درباره مرکز تحقیقات میکروب شناسی
مرکز تحقیقات میکروب شناسی مولکولی دانشگاه شاهد در سال 1389 با هدف ارتقاء و توسعه مطالعات حوزه میکروب شناسی، در دانشگاه شاهد راه اندازی شد. این مرکز در آذر ماه 1390 موفق به اخذ موافقت اصولی و در دی ماه سال 1394 موفق به اخذ موافقت قطعی از شورای گسترش وزارت بهداشت ، درمان و آموزش پزشکی گردید.
دسترسی سریع
اخبار مرکز
اطلاعیه مرکز
15 بهمن 1403
.
کارگاههای تخصصی مرکز در بهمن و اسفند ماه 1403
15 بهمن 1403
.
کارگاههای تخصصی مرکز در بهمن و اسفند ماه 1403
15 بهمن 1403
.
کارگاههای تخصصی مرکز در بهمن و اسفند ماه 1403
5 شهریور 1403
.
کارگاهها و وبینارهای تخصصی مرکز در شهریور ماه 1403
12 دی 1402
تیم ارزیابی اعتباربخشی وزارت بهداشت، درمان و آموزش پزشکی روز یکشنبه 28 آبان در مجتمع مراکز تحقیقاتی حضور یافتند و پس از برگزاری جلسه ای با مسوولان مراکز، از مراکز تحقیقاتی گروه پزشکی بازدید نمودند.